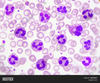
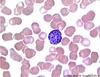
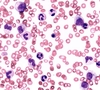

Haematology Flashcards
(157 cards)
What is alpha thalassaemia trait?
1/2 genes missing
What is the management of spherocytosis?
Splenectomy
What infection can be gained from RBC?
Pseudomonas
What is myelofibrosis?
Bone marrow is replaced with fibrous tissue
Where are the beta genes?
Chromosome 11 - one on each
What is the INR target for recurrent DVT/PE?
3-4
What is the presentation of ALL?
Fatigue
bleeding
Bruising
Infections
Splenomegaly
What is seen on the blood film in G6PD deficiency?
Heinz bodies
Which disease is the HFE gene a part of?
Haemachromatosis
What do schistocytes indicate?
Intravascular haemolysis
How can autoimmune haemolytic anaemias be typified?
Warm and cold
What is a sickle cell crisis?
Episodes of tissue infarction due to vascular occlusion
What is associated with warm AI haemolytic anaemia?
SLE Lymphoma Leukaemias Mefenamic acid
What is seen on blood film in CLL?
‘Smear cells’, lots of small mature lymphocytes
Which age group commonly gets CML?
40-60 year olds
What is this cell?

Eosinophil
What is the treatment of a painful sickle cell crisis?
Opiate analgesia Hydration Rest oxygen ?transfusion?
What is this?

Howell-Jolly body
What is the INR target for AF?
2-3
What is priapism associated with?
Sickle cell anaemia
What is polycythaemia rubra vera?
Increase in RBCs
What special type of cells are seen in Hodgkins lymphoma and what do they look like?
Reed-Sternberg cells ‘owl’s eye’

What is the management of essential thrombocytopenia?
Aspirin Hydroxycarbamide Interferon alpha
What is seen on the blood film in myelofibrosis?
Tear drop RBC, leucoerythroblastic change - nucleated RB + myelocytes